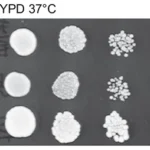

Корейский стартап испытал гибридную ракету для космоса
Корейская компания Innospace, проанализировав данные полета, заявила, что первое испытание ее гибридного двигателя, установленного на одноступенчатом демонстраторе, прошло успешно. Запуск был осуществлен из космического центра Алкантара в Бразилии.
Эта небольшая ракета, названная Hanbit-TLV (Hanbit Test Launch Vehicle), совершила суборбитальный полет и, по словам компании, станет первой в мире в категории (потенциально) орбитальных аппаратов с гибридной технологией. Hanbit-TLV — это ракета высотой 16,3 метра и диаметром 1 метр, весом 8,4 тонны.
Целью испытаний была проверка летных характеристик гибридного двигателя тягой 150 кН, работающего на жидком кислороде и парафиновом топливе. Этот двигатель будет входить в состав первой ступени ракеты-носителя Hanbit-Nano. Она предназначена для вывода полезной нагрузки весом до 50 кг на гелиосинхронную орбиту высотой 500 км с помощью двух ступеней и должна поступить в эксплуатацию в 2024 году.
Первый полет Innospace
Во время полета двигатель устойчиво горел в течение 106 секунд, неся SISNAV, инерциальную навигационную систему весом 20 кг от DCTA, бразильского департамента аэрокосмических наук, а затем опустился на заранее определенную площадку.
Стартап работает в области пусковых установок для малых спутников, в частности, с гибридным топливом, и имеет три продукта для трех различных классов полезной нагрузки: 50 кг, 150 кг и 500 кг. Генеральный директор компании Ким Су Чонг говорит, что успех испытаний является подтверждением способности Innospace выйти на рынок ракет-носителей, а также демонстрацией того, что у компании есть технологии для их самостоятельной разработки.
Кроме того, уже разработаны планы по созданию еще одной тестовой версии двигателя, на этот раз с тягой 3 тонны, которая вместе с 15-тонным двигателем завершит создание двигательной установки для Hanbit-Nano. Технологии разделения ступеней и обтекателей все еще находятся в стадии разработки. Важно подчеркнуть, что компания Innospace самостоятельно разработала, построила и собрала двигатель.
Innospace, учитывая этот крупный успех, может стать пионером в дисциплине запуска малых коммерческих спутников во всем мире. В прошлом году компания подписала пятилетнее соглашение об использовании бразильского космического центра Алкантара, в то время как ведутся переговоры о заключении еще одного соглашения с норвежским космодромом на острове Андёйя, запланированного на этот год.
Кроме того, компания также ищет место для запуска на азиатской земле, чтобы привлечь региональных клиентов. На данный момент ожидаемыми клиентами Hanbit-Nano являются стартапы и исследовательские институты в Азии, Европе и Латинской Америке, ориентированные на создание кубсатов. Реальным и окончательным испытательным полигоном для таких малых ракет-носителей, безусловно, станет рынок, учитывая эволюцию нескольких первых поколений стартапов в сторону все более крупных ракет-носителей.
Технология гибридного двигателя
Чтобы функционировать, ракета всегда использует принцип действия-реакции, или третий принцип динамики Ньютона. Независимо от ее топливной системы. Внутри ракеты образуются выхлопные газы высокого давления и высокой температуры, которые затем с очень большой скоростью выбрасываются наружу, создавая тягу в противоположном направлении. Такие аппараты принято называть эндореакторами, поскольку они несут все необходимое для создания тяги внутри себя, и противопоставляются экзореакторам, которым, напротив, для работы требуется внешний компонент (обычно воздух).
Гибридные двигатели, такие как Innospace или Virgin Galactic, состоят из бака, содержащего жидкий окислитель, и камеры сгорания, содержащей твердое топливо. Сгорание происходит в зоне, прилегающей к стенкам твердого топлива, после того как окислитель испаряется и подается в камеру сгорания.

Целью гибридной технологии является создание двигателей с характеристиками, находящимися где-то между жидкостным и твердым топливом, обладающих как недостатками, так и преимуществами. Основными преимуществами являются высокий удельный импульс, простота выключения и регулировки тяги, меньшая сложность системы подачи жидкого топлива и, прежде всего, меньший риск при производстве, транспортировке и обращении с твердотопливными двигателями, поскольку окислитель и топливо хранятся отдельно. Основным недостатком является большая сложность по сравнению с твердотопливными ракетами.
Innospace может представлять собой хорошую возможность для обеспечения доступа на орбиту для небольших полезных нагрузок. Неизвестной остается цена, которая должна быть конкурентоспособной. Однако, благодаря успешному испытанию, корейская компания позиционирует себя как потенциальный ориентир для гибридных двигательных технологий, применяемых в ракетах-носителях на мировой космической арене.